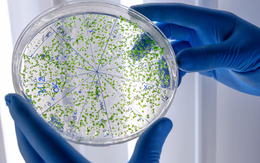
AI tìm ra 'tử huyệt' ngăn vi rút xâm nhập tế bào

Tại triển lãm công nghệ lớn nhất thế giới CES 2026, công ty khởi nghiệp Strutt từ Singapore trình làng sản phẩm xe lăn thông minh trang bị AI, biết 'nghe lời' người dùng.

Khi diện tích rừng tự nhiên suy giảm, muỗi tại Brazil chuyển mục tiêu sang con người, làm tăng nguy cơ lây truyền các vi rút như sốt xuất huyết, Zika, Chikungunya.

Nghiên cứu cho thấy gene Foxo1 bảo vệ tim và miễn dịch khi còn trẻ nhưng lại gây tổn thương nghiêm trọng, làm tăng nguy cơ tử vong lúc về già.

Nghiên cứu mới cho thấy não phi hành gia có thể thay đổi hình dạng và dịch chuyển vị trí khi sống lâu trong không gian, đặt ra thách thức cho sứ mệnh Mặt trăng, sao Hỏa.

Một atlat miễn dịch quy mô chưa từng có cho thấy hệ miễn dịch khác nhau rõ rệt giữa các quần thể, đặt lại nền tảng cho y học cá thể hóa.

Một nghiên cứu mới chỉ ra tán tỉnh không chỉ vì rung động, mà còn phản ánh tính cách, động cơ và mục đích cá nhân của mỗi người.

Kết quả nghiên cứu mới củng cố giả thuyết ARN xuất hiện trước ADN, thay đổi cách nhìn về lịch sử sự sống trên Trái đất.

Trước áp lực phát thải từ xây dựng, các nhà khoa học Đức thử nghiệm vật liệu từ nấm: nhẹ, bền, ít CO₂, hướng tới thay thế bê tông trong tương lai.

Nghiên cứu cho thấy trẻ dưới 2 tuổi tiếp xúc sớm với màn hình thiết bị điện tử như điện thoại hay máy tính bảng có nguy cơ thay đổi cấu trúc não, chậm quyết định và dễ lo âu khi lớn.

Các nhà khoa học Nga vừa công bố chế tạo thành công máy tính lượng tử dựa trên ion đầu tiên của Nga, đánh dấu một bước tiến quan trọng trong lĩnh vực công nghệ lượng tử.

Các nhà khoa học Trung Quốc thành công tạo ra giống cá diếc không xương dăm hình chữ Y nhờ công nghệ chỉnh sửa gene CRISPR/Cas9.

Thử nghiệm này đã lập nên một cột mốc mới, biến phương tiện trở thành tàu đệm từ điện siêu dẫn nhanh nhất thế giới hiện nay.

Máy nướng bánh mì, nồi chiên không dầu, máy sấy tóc có thể phát thải lượng lớn hạt siêu mịn, tiềm ẩn rủi ro cho sức khỏe, nhất là trẻ em.

Trung Quốc lần đầu chế tạo thành công kim loại hai chiều, thành tựu từng bị coi là không thể, được Physics World vinh danh Top 10 đột phá vật lý 2025.

Hàng nghìn dấu chân khủng long hơn 200 triệu năm vừa lộ diện trên vách núi dựng đứng ở miền Bắc Ý, gần nơi tổ chức Olympic Mùa đông 2026.

Nghiên cứu mới cho thấy đồ bảo hộ 'không hóa chất vĩnh cửu PFAS' của lính cứu hỏa lại chứa chất chống cháy gốc brom, tiềm ẩn nguy cơ ung thư và rối loạn tuyến giáp.
Nhờ AI, các nhà khoa học Mỹ phát hiện 'công tắc' phân tử then chốt, vô hiệu hóa vi rút herpes ngay khi vừa tìm cách xâm nhập tế bào.

Một nghiên cứu mới của Đại học Cambridge cho thấy loài người không phải chung thủy nhất như nhiều người vẫn nghĩ, mà 'ngôi vị' này thuộc về hải ly.

Bằng chứng tại Barnham (Anh) cho thấy con người cổ đại đã chủ động tạo và giữ lửa từ 400.000 năm trước, sớm hơn 350.000 năm so với hiểu biết trước đây.

Những người làm việc, sinh hoạt trong điều kiện thiếu sáng vào buổi sáng được ghi nhận bị rối loạn hormone, đảo lộn giấc ngủ và tâm trạng u ám kéo dài, tăng nguy cơ trầm cảm.











